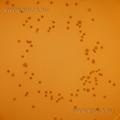
SS-Agar (Salmonella Shigella Agar)
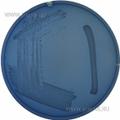
Simmons Citrate Agar
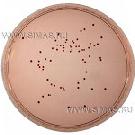
Slanetz and Bartley Medium (Membrane Enterococcus Agar)
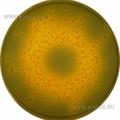
T.C.B.S. Cholera Medium
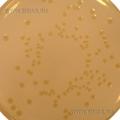
Tryptone Soya Agar USP (Soybean Casein Digest Medium)

Подписаться на рассылку
Компания СИМАС
Москва, Варшавское шоссе д.125 стр.1
+7 (495) 980 - 29 - 37, +7 (916) 942 - 65 - 95
info@simas.ru
|
Полный перечень сред Lab M
1 | 2 | 3 | 4 | 5 | 6 | 7
Ringers Solution 1/4 Strength Tablets
 Производитель: Lab M
Описание: Ringers Solution 1/4 Strength Tablets — таблетки для приготовления осмотического раствора Рингера.
Этап: Исследование |
|
|
|
Rose Bengal Chloramphenicol Agar
 Производитель: Lab M
Описание: Агар селективный с бенгальским розовым и хлорамфениколом для подсчета дрожжей и плесеней.
Этап: Исследование |
|
|
|
SS-Agar (Salmonella Shigella Agar)
Производитель: Lab M
Описание: SS-агар для выделения сальмонелл и шигелл.
Этап: Исследование |
|
|
|
Sabouraud Dextrose Agar
 Производитель: Lab M
Описание: Агар декстрозный Сабуро, селективный для грибов и дрожжей.
Этап: Исследование |
|
|
|
Sabouraud Liquid Medium USP
 Производитель: Lab M
Описание: Среда Сабуро жидкая для контроля на стерильность фармпрепаратов в соответствии с требованиями Фармакопеи США.
Этап: Исследование |
|
|
|
Sabouraud Maltose Agar
 Производитель: Lab M
Описание: Агар Сабуро с мальтозой для выделения грибов и дрожжей по рекомендации АРНА.
Этап: Исследование |
|
|
|
Selenite Broth Base
 Производитель: Lab M
Описание: Бульон cеленитный (c биселенитом натрия) для селективного обогащения сальмонелл в образцах продуктов и фекалий. Рекомендовано использование вместе со средой LAB044B.
Этап: Исследование |
|
|
|
Selenite Cystine Broth Base
 Производитель: Lab M
Описание: Бульон селенитный с цистином для селективного обогащения сальмонелл в образцах продуктов и фекалий. Рекомендовано использование вместе со средой LAB044B.
|
|
|
|
Sensitivity Test Agar (STA)
 Производитель: Lab M
Описание: Агар STA для определения чувствительности бактерий к антибиотикам по методу Joan Stokes.
Этап: Исследование |
|
|
|
Skirrow Selective medium (Blood Agar № 2)
 Производитель: Lab M
Описание: Агар селективный Скирроу для выделения кампилобактерий.
Этап: Исследование |
|
|
|
Sodium biselenite
 Производитель: Lab M
Описание: Биселенит натрия, добавка к селенитным средам.
Этап: Исследование |
|
|
|
Susceptibility Test «ISO» Agar
 Производитель: Lab M
Описание: Агар определенного состава для определения чувствительности бактерий к антибиотикам.
Этап: Исследование |
|
|
|
Simmons Citrate Agar
Производитель: Lab M
Описание: Агар цитратный Симмонса для дифференциации энтеробактерий.
Этап: Исследование |
|
|
|
Slanetz and Bartley Medium (Membrane Enterococcus Agar)
Производитель: Lab M
Описание: Агар Слэнитца-Бэртли для выделения энтероккоков из воды методом мембранных фильтров.
Этап: Исследование |
|
|
|
Sorbitol MacConkey Agar
 Производитель: Lab M
Описание: Агар селективно-дифференциальный для выделения энтеротоксигенных типов E.coli O-157.
Этап: Исследование |
|
|
|
Sugar Free Agar
 Производитель: Lab M
Описание: Агар безуглеводный для подсчета психротрофных и мезофильных грам (-) бактерий в молочных продуктах.
Этап: Исследование |
|
|
|
T.C.B.S. Cholera Medium
Производитель: Lab M
Описание: Агар TCBS для селективного выделения вибрионов Vibrio spp.
Этап: Исследование |
|
|
|
Terrific Broth
 Производитель: Lab M
Описание: Бульон высокопитательный для получения густых суспензий бактерий.
Этап: Исследование |
|
|
|
Tetrathionate Broth (APHA)
 Производитель: Lab M
Описание: Бульон тетратионатный для селективного обогащения сальмонелл (по рекомендации АРНА).
Этап: Исследование |
|
|
|
Thayer Martin Medium
 Производитель: Lab M
Описание: Thayer Martin Medium - агар (основа) для селективного выделения Neisseria gonorrhoeae и Neisseria meningitidis.
Этап: Исследование |
|
|
|
Thioglycollate Medium (Brewer)
 Производитель: Lab M
Описание: Среда тиогликолевая (по Бреверу) для микробиологического контроля стерильности и культивирования анаэробов.
Этап: Исследование |
|
|
|
Todd Hewitt Broth
 Производитель: Lab M
Описание: Бульон Тодда-Хьюита для культивирования стрептококков перед серотипированием.
Этап: Исследование |
|
|
|
Triple Sugar Iron Agar
 Производитель: Lab M
Описание: Агар трехсахарный с железом для дифференциации энтеробактерий.
Этап: Исследование |
|
|
|
Tryptone Bile Agar
 Производитель: Lab M
Описание: Агар триптонный желчный для выделения и подсчета Escherichia coli.
Этап: Исследование |
|
|
|
Tryptone Glucose Extraсt Agar
 Производитель: Lab M
Описание: Агар триптонный с глюкозой для определения общего количества живых клеток микрооганизмов в продуктах питания и молочных продуктах, рекомендован ассоциациями АРНА и АОАС.
Этап: Исследование |
|
|
|
Tryptone Soya Agar USP (Soybean Casein Digest Medium)
Производитель: Lab M
Описание: Агар триптонно-соевый (на основе перевара казеина и сои) по Фармакопее США. Среда общего употребления для выращивания широкого круга бактерий.
Этап: Исследование |
|
|
|
Tryptone Soya Broth USP (Soybean Casein Digest Medium)
 Производитель: Lab M
Описание: Бульон триптонно-соевый (на основе перевара казеина и сои) по Фармакопее США. Среда общего употребления для выращивания широкого круга бактерий.
Этап: Исследование |
|
|
|
Tryptone Soya Broth (without Dextrose)
 Производитель: Lab M
Описание: Бульон триптонно-соевый - основа для внесения углеводов и изучения ферментативных свойств микроорганизмов.
Этап: Исследование |
|
|
|
Tryptone Water
 Производитель: Lab M
Описание: Среда- вода триптонная для выявления способности бактерий продуцировать индол из триптофана.
Этап: Исследование |
|
|
|
Tryptose Phosphate Broth
 Производитель: Lab M
Описание: Бульон триптозо-фосфатный, универсальная и высокопитательная среда.
Этап: Исследование |
|
|
|
1 | 2 | 3 | 4 | 5 | 6 | 7
|